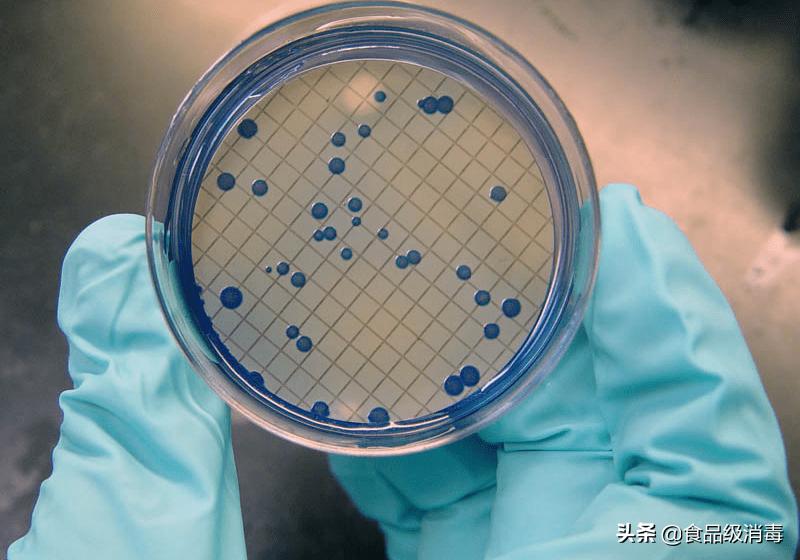
化妆品中微生物的危害视频,化妆品微生物污染

化妆品生产中的污染因素
微生物对化妆品的污染,不仅影响产品本身的质量,而更严重的是它危及消费者的健康和安全,从化妆品整个生产过程来看,微生物污染又分为直接污染和二次污染,这些污染对化妆品的质量都是致命影响,那么对于微生物的污染我们应该如何解决呢?
首先要准确找到微生物污染的具体原因,并对污染源进行有效的消毒和灭菌工作,针对不同的污染源可以采用不同的消毒灭菌方式
消毒和灭菌定义:

消毒与灭菌的定义
常用的灭菌方式:
化学试剂法:通过破坏其蛋白质的分子结构,使蛋白质变性,达到灭菌的效果。
过滤灭菌法:用筛除或滤材吸附等物理方式除去微生物。分为液体过滤和空气过滤,像化妆品的洁净车间的中央空调就可以利用空气过滤的方法达到除菌,可分为初效、中效及高效过滤,需要每年定期更换滤网,并做好记录。
辐射灭菌法:利用辐射产生的能量进行杀菌的方法称辐射灭菌,常见的有α-射线、β-射线、γ-射线、X-射线、微波、臭氧、紫外线、日光等。
加热灭菌法:通过高温来杀死微生物的方法。可分干热灭菌和湿热灭菌两种。

欧盟对化妆品微生物限量标准
化学试剂灭菌法
甲醛: 最早被工厂使用于灭菌,因为它对所有的微生物都有杀灭作用,包括细菌繁殖体、芽孢、真菌和病毒,但是它的灭杀效果同环境温度和湿度影响较大,且甲醛有致癌作用,故目前这种方法使用较少。
酒精 :杀菌最适宜浓度为75%左右,过高或过低都达不到效果,但酒精不能彻底杀死细菌内部细胞,用途广泛、较为经济,适合用于清洗和擦拭仪器。
双氧水: 只能杀灭细菌,不能杀大部分真菌,它的用途广泛、较为经济,但高浓度过氧化氢有强烈的腐蚀性,吸入该品蒸气或雾对呼吸道有强烈刺激性。建议使用的浓度在10%左右。
84消毒液(次氯酸钠) :只能杀灭细菌,不能杀大部分真菌,它的用途广泛、较为经济,但是会腐蚀、不稳定、有致癌物。建议使用浓度在5.5-6.5%的有效氯浓度
二氧化氯: 属高效消毒剂,具有广谱、速效杀菌作用。能杀灭细菌、病毒、寄生生物,部分真菌,具有安全、高效、无三致的优点,但它的配置复杂,需特定发生器,且有刺激性气味,所以未被广泛使用。建议使用浓度在0.5-10ppm。
菌落总数超标
辐射灭菌法
臭氧: 能杀灭细菌、病毒、寄生生物,部分真菌,能广泛控制细菌活动,缺点是它不稳定、成本高、有腐蚀性和安全的问题。采用20mg/m3 浓度的臭氧,作用 30min。用臭氧消毒空气,必须是在封闭空间,且室内无人条件下进行,消毒后至少过 30min 才能进入。
紫外线: 能够杀死一切微生物,包括细菌、结核菌,优点是不受酸碱度及温度的影响,不会留下味道及气味,低毒性,缺点是渗透力低,安全问题,细菌重新滋生,受外在因素影响,成本高。在室内无人条件下,可采取紫外线灯悬吊式或移动式直接照射。紫外线消毒灯(功率:30W,在1.0m 处的强度 >70μW/cm2)的数量为平均每m3不少于 1.5W,照射时间不少于30min。
微波: 通过微生物细胞中水分子的震动后短时产生热能达到灭菌效果。优点是速度快,操作方便,缺点是加热灭菌的不均匀性。
加热灭菌法
干热灭菌: 利用灼烧或干热空气灭菌而没有饱和水蒸气参加的灭菌方法,像火焰灼烧、热空气灭菌(电热恒温干燥箱)都属于干热灭菌法。优点是方法简单,故在生产上广泛应用,缺点是对于使用的材质有要求。灭菌条件为:160℃,2h ;或者170℃,1h;或者180℃,30min。
湿热灭菌: 是利用蒸汽进行灭菌的。湿热灭菌又可分为高压、常压、间歇灭菌和巴氏灭菌4种。
① 高压蒸汽灭菌: 利用高压蒸汽的较强的穿透力和较常压高的温度进行杀菌,能大大缩短灭菌时间,提高工作效率。在热蒸汽条件下,细菌的芽孢在120℃,经20~30min可全部被杀死。这种方法适用于各种耐热物品的灭菌,如一般培养基、生理盐水等各种溶液、玻璃器皿、工作服等。
② 常压蒸汽灭菌: 利用自然压力、100℃蒸汽进行灭菌的。它设备简单、成本低,只需要搭建一个灶即可,一般水烧开后保持8~10小时,闷一夜就能完成杀菌。
③ 常压间歇蒸汽灭菌: 利用常压蒸汽反复几次灭菌的方法,该方法可用于不耐高温的药品、营养物、特殊培养基的灭菌。
④ 低温巴氏灭菌: 在60~70℃下,经一定时间,杀死有害微生物的方法,适应于不耐高温的物品消毒。
奥克泰士来自德国,是广谱、生态型消毒剂,不含重金属,无毒、无残留。改变单纯过氧化氢稳定性差,消毒效果不理想的特点

过氧化氢复合型消毒
▲具备高效的杀菌能力 奥克泰士能够杀灭包括大肠杆菌,霉菌,酵母菌、金黄色葡萄球菌,沙门氏菌等在内的200多种有害微生物,甚至能够杀灭芽孢和病毒。广泛应用于制药厂,食品厂,日化厂等消毒灭菌。
▲具备高适用性 不受温度,光照,PH值影响,这点几乎克服了其他所有消毒产品的缺点,我们知道目前的消毒产品,无一例外的会受到PH值,温度的影响,从而失效或者需要增加用量(用量的增加,意味着腐蚀性,浓度的增加,意味着易清洗程度增加)。
▲不会产生耐药性 不同于二氧化氯和抗生素类产品,独特的杀菌原理,不会产生抗药性,因此在企业生产中,可以解决如下两个问题:
1) 消毒产品使用量会递增,使用奥克泰士是不会出现使用量递增的情况
2)传统消毒产品使用一段时间后无效或者效果不稳定,不产生耐药性的产品,因此可以长期使用。